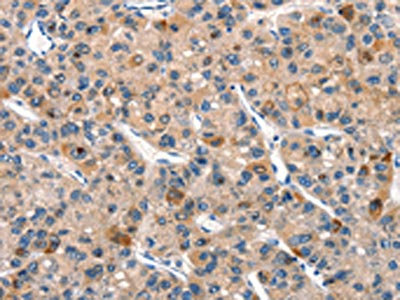

-
中文名稱:DUSP2兔多克隆抗體
-
貨號:CSB-PA094054
-
規格:¥1100
-
圖片:
-
The image on the left is immunohistochemistry of paraffin-embedded Human thyroid cancer tissue using CSB-PA094054(DUSP2 Antibody) at dilution 1/30, on the right is treated with synthetic peptide. (Original magnification: ×200)
-
The image on the left is immunohistochemistry of paraffin-embedded Human liver cancer tissue using CSB-PA094054(DUSP2 Antibody) at dilution 1/30, on the right is treated with synthetic peptide. (Original magnification: ×200)
-
Gel: 8%SDS-PAGE, Lysate: 40 μg, Lane: Hela cells, Primary antibody: CSB-PA094054(DUSP2 Antibody) at dilution 1/300, Secondary antibody: Goat anti rabbit IgG at 1/8000 dilution, Exposure time: 1 minute
-
-
其他:
產品詳情
-
Uniprot No.:
-
基因名:
-
別名:Dual specificity phosphatase 2 antibody; Dual specificity protein phosphatase 2 antibody; Dual specificity protein phosphatase PAC 1 antibody; Dual specificity protein phosphatase PAC-1 antibody; DUS2_HUMAN antibody; DUSP 2 antibody; DUSP2 antibody; PAC 1 antibody; PAC1 antibody; Serine/threonine specific protein phosphatase antibody
-
宿主:Rabbit
-
反應種屬:Human,Mouse
-
免疫原:Synthetic peptide of Human DUSP2
-
免疫原種屬:Homo sapiens (Human)
-
標記方式:Non-conjugated
-
抗體亞型:IgG
-
純化方式:Antigen affinity purification
-
濃度:It differs from different batches. Please contact us to confirm it.
-
保存緩沖液:-20°C, pH7.4 PBS, 0.05% NaN3, 40% Glycerol
-
產品提供形式:Liquid
-
應用范圍:ELISA,WB,IHC
-
推薦稀釋比:
Application Recommended Dilution ELISA 1:1000-1:2000 WB 1:200-1:1000 IHC 1:25-1:100 -
Protocols:
-
儲存條件:Upon receipt, store at -20°C or -80°C. Avoid repeated freeze.
-
貨期:Basically, we can dispatch the products out in 1-3 working days after receiving your orders. Delivery time maybe differs from different purchasing way or location, please kindly consult your local distributors for specific delivery time.
-
用途:For Research Use Only. Not for use in diagnostic or therapeutic procedures.
相關產品
靶點詳情
-
功能:Regulates mitogenic signal transduction by dephosphorylating both Thr and Tyr residues on MAP kinases ERK1 and ERK2.
-
基因功能參考文獻:
- Regulation of atypical MAP kinases ERK3 and ERK4 by the phosphatase DUSP2 has been reported. PMID: 28252035
- hypoxia-induced IL-6 production in endometriotic lesions is mediated via downregulation of DUSP2, which causes aberrant activation of STAT3 signaling pathway and helps the endometriotic cells survive under the ectopic environment PMID: 28440564
- Authors report that hypoxia-mediated downregulation of the dual specificity phosphatase 2 (DUSP2) is critical for the accumulation of CSC in colorectal cancer. PMID: 28652251
- Hypoxia inhibits DUSP2 expression in colon cancer, leading to up-regulation of IL-8, which facilitates angiogenesis and tumour metastasis. PMID: 28026024
- Our data show that aberrant epigenetic inactivation of DUSP2 occurs in carcinogenesis and that CTCF is involved in the epigenetic regulation of DUSP2 expression. PMID: 26833217
- Highly recurrent mutation of DUSP2 is associated with nodular lymphocyte predominant Hodgkin lymphoma. PMID: 26658840
- identified among the key genes in circulating monocytes that were altered by exercise PMID: 26207425
- Data show that hypoxia promotes lapatinib resistance in ERBB2-positive breast cancer cells through activation of the MEK-ERK pathway a HIF-1-dependent manner via regulation of dual-specificity phosphatase 2 (DUSP2). PMID: 25596742
- DUSP2 is an important molecule in endometrial physiology and that hypoxia-inhibited DUSP2 expression is a critical factor for the development of endometriosis. PMID: 21984126
- Dipyridamole reduced expression of PAC-1 and CD62p in patients with malignant lymphoma. PMID: 20723301
- DUSP2 is a key downstream regulator of HIF-1-mediated tumor progression and chemoresistance PMID: 21490398
- During apoptosis, p53 activates transcription of PAC1 by binding to a palindromic site in the PAC1 promoter PMID: 12673251
- relationships between the expression levels of CD61, CD63, and PAC-1 on the platelet surface and the incidences of acute rejection and tubular necrosis as well as the recovery of graft function after renal transplantation PMID: 12826159
- variation in large granular lymphocyte leukemia PMID: 14680939
- These results reveal a crucial role of PAC1 in E2F-1-directed apoptosis. PMID: 17471234
- Induction of hypercortisolism in healthy volunteers was not associated with changes in the platelet activation marker PAC-1 or the number of circulating platelet-leucocyte aggregates. PMID: 18600034
顯示更多
收起更多
-
亞細胞定位:Nucleus.
-
蛋白家族:Protein-tyrosine phosphatase family, Non-receptor class dual specificity subfamily
-
組織特異性:Expressed in hematopoietic tissues.
-
數據庫鏈接:
Most popular with customers
-
YWHAB Recombinant Monoclonal Antibody
Applications: ELISA, WB, IHC, IF, FC
Species Reactivity: Human, Mouse, Rat
-
Phospho-YAP1 (S127) Recombinant Monoclonal Antibody
Applications: ELISA, WB, IHC
Species Reactivity: Human
-
-
-
-
-
-